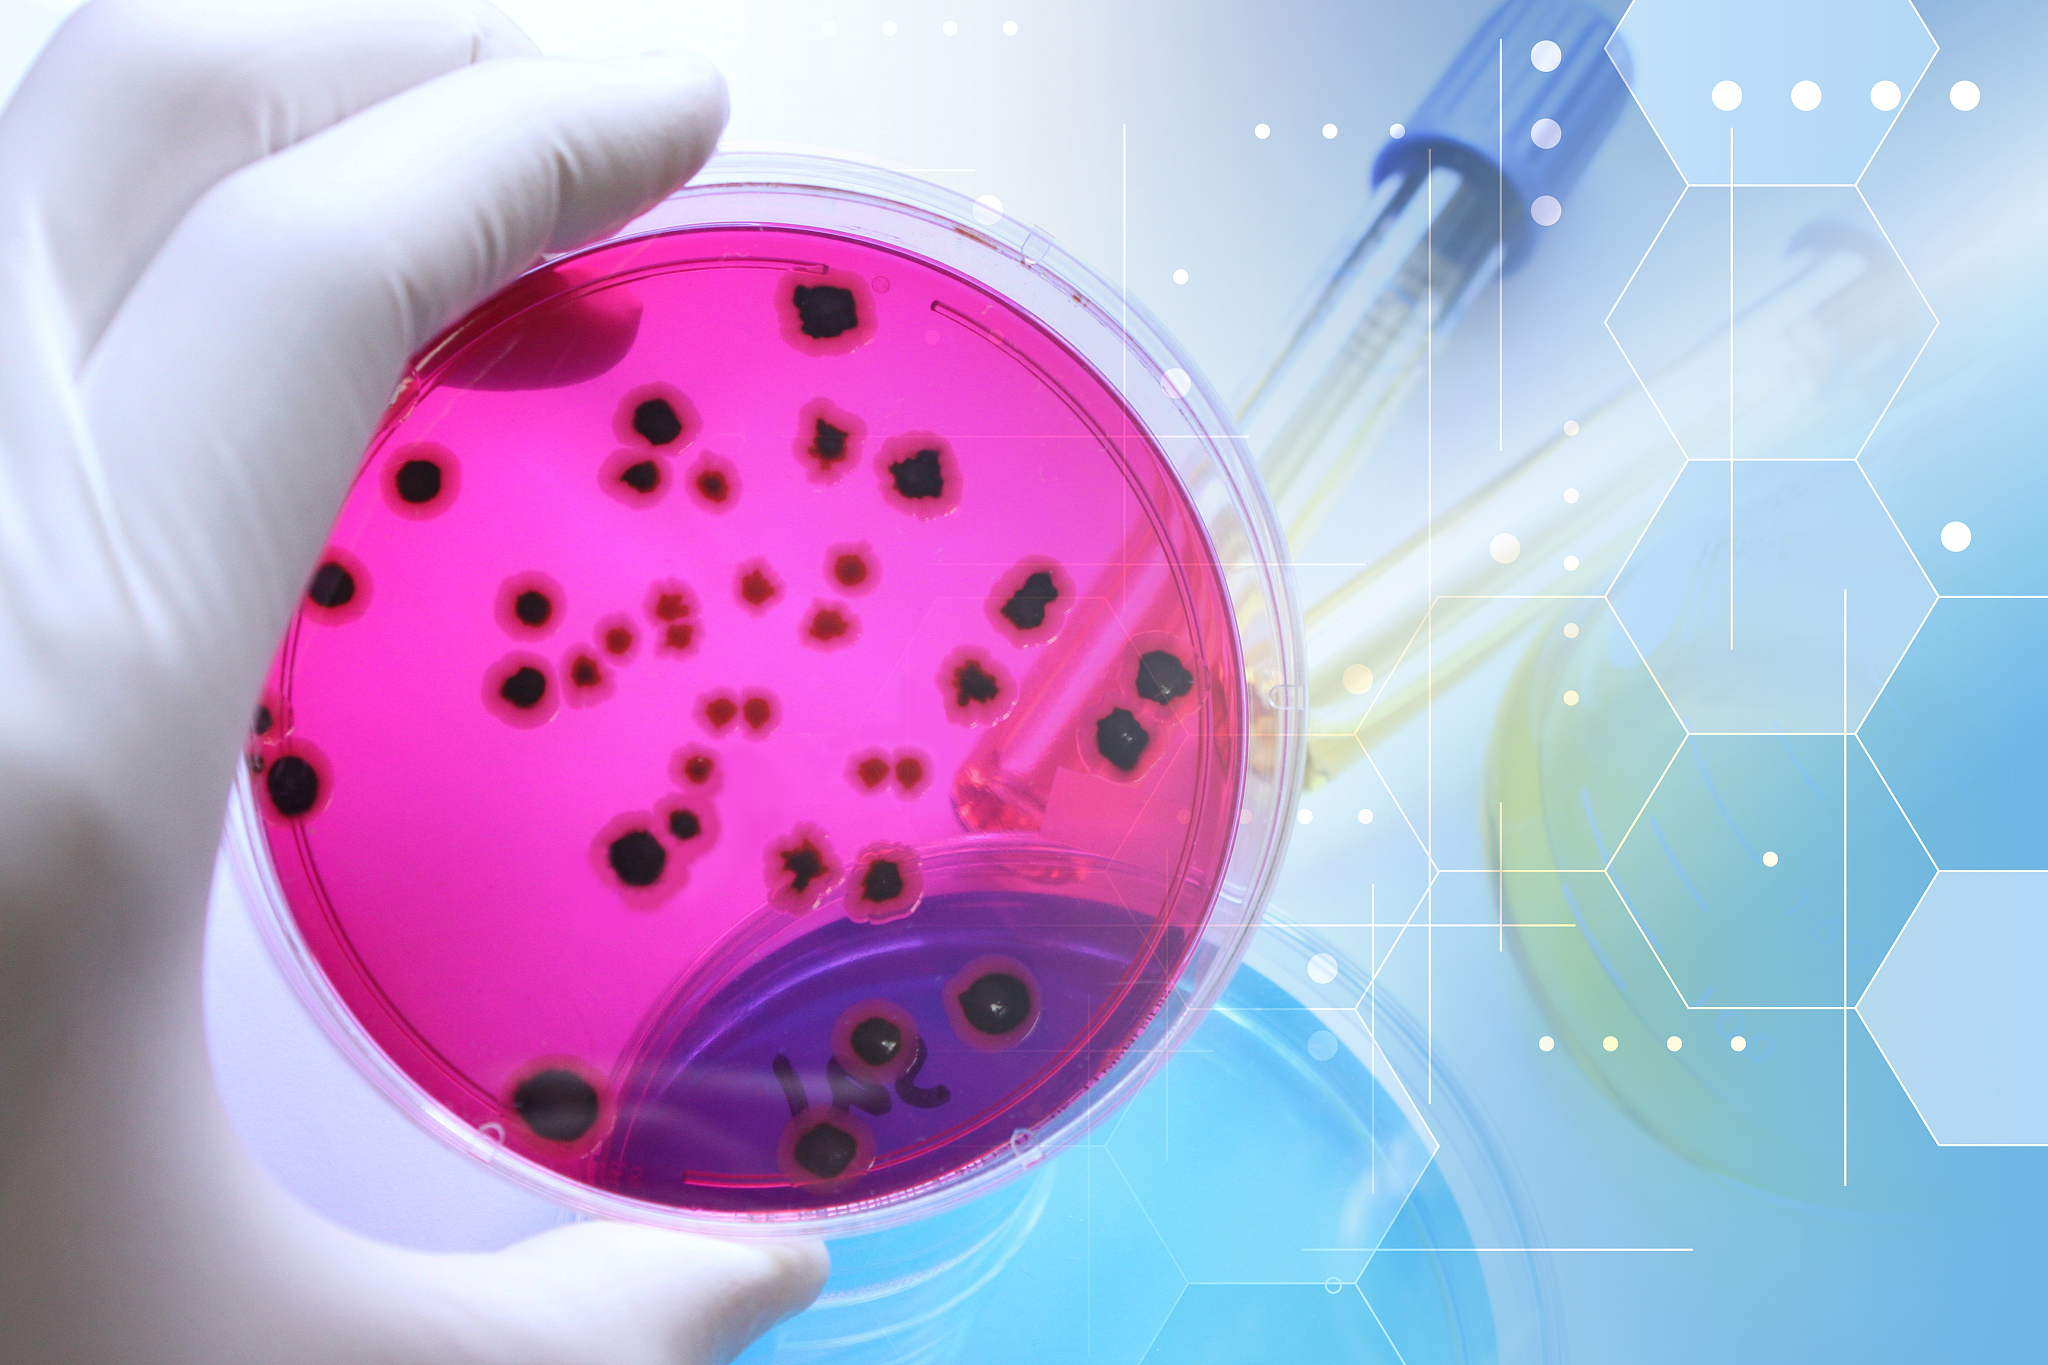
以小明好朋友的视角写一篇2000字记叙文以小明和我病情为线索：小明和我一起吃路边摊都感染病毒在学校拉肚子五天的惨痛经历。详细写学校上课时憋不住请假上厕所一拉就是10几分钟一天泻七八次。中午我也开始拉肚子第二天小明和我一起请假看医生第三天病情好转小明又开始乱吃东西生鸡蛋冰牛奶我还在严重拉肚子一天拉了10几次第四天我已经康复小明并不知道自己已经感染沙门氏菌去学校病情恶化小明一天拉肚子达20多次厕所逐渐

以小明好朋友的视角写一篇2000字记叙文以小明和我病情为线索:小明和我一起吃路边摊都感染病毒在学校拉肚子五天的惨痛经历。详细写学校上课时憋不住请假上厕所一拉就是10几分钟一天泻七八次。中午我也开始拉肚子第二天小明和我一起请假看医生第三天病情好转小明又开始乱吃东西生鸡蛋冰牛奶我还在严重拉肚子一天拉了10几次第四天我已经康复小明并不知道自己已经感染沙门氏菌去学校病情恶化小明一天拉肚子达20多次厕所逐渐
小明是我最好的朋友,我们从小一起长大,无话不谈。记得有一次,我们一起去路边摊吃夜宵,却没想到这次的经历会给我们带来如此痛苦的回忆。
那天晚上,小明和我决定去尝试一下路边摊的小吃。我们边走边聊,一路欢快地走到了一个小摊前。摊主是一个和蔼可亲的中年人,看到我们两个兴高采烈地点了一些食物,他热情地为我们准备着。谁知道,这顿夜宵竟成了我们的噩梦开始。
第二天,我在学校上课时突然感觉到一阵腹痛,慌忙请假冲向厕所。一拉就是十几分钟,一天竟然泻了七八次。这种痛苦的经历让我彻底失去了上课的兴致,只想找一个安静的地方躺下来。
中午,我发现小明也开始有了同样的症状。我担心地询问他感觉如何,他脸色苍白地告诉我他也在拉肚子。于是,第二天我们一起请假去看医生。
第三天,医生给我们开了药,我们的病情有所好转。但是,小明似乎对医生的话不以为然,他又开始乱吃东西,例如生鸡蛋、冰牛奶等。而我却还在严重拉肚子,一天竟然拉了十几次。我劝告小明要注意饮食,可他似乎并不在意。
第四天,我已经康复了。然而,小明却并不知道自己已经感染了沙门氏菌。他依然坚持去学校上课,但他的病情却逐渐恶化。一天拉肚子竟然达到了二十多次,厕所几乎成为了他的"家"。我看着他的样子心痛不已,希望他能够早日康复。
那一个星期,小明的肠胃从健康变得很差。三天两头拉肚子,他经常因为病情而缺席学校。我看着他的样子,心生后悔。如果当初他能够听从医生的建议,不乱吃东西,也许他的病情不会恶化到这种地步。
小明经历了一段痛苦的时期后,终于明白了生活中的健康重要性。他下定决心改变自己的饮食习惯,开始注重健康饮食。他开始吃一些易消化的食物,同时也避免吃一些不干净的食物。
时间过去了一年,小明的肠胃状况有所好转。他再也没有像以前那样频繁地拉肚子了。他告诉我,他从那次的经历中学到了很多,明白了健康的重要性。他感激地说,如果没有那次的病痛,他可能永远不会懂得珍惜自己的健康。
这次的经历让我们明白了一个道理,健康是最重要的财富。我们要时刻保持良好的饮食习惯,注重身体的健康。无论是在吃路边摊还是在生活中,我们都应该慎重选择食物,避免食物中毒和细菌感染的发生。因为只有拥有健康的身体,我们才能够更好地享受生活,追逐自己的梦想
原文地址: https://www.cveoy.top/t/topic/imUN 著作权归作者所有。请勿转载和采集!